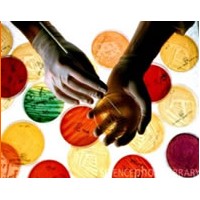
LACMAC logo - Similar company to Wasser Farma

Company Details
- Employees
- 34
- Address
- Rua José Bonifácio, 29 – Todos Os Santos, Rio De Janeiro,rio De Janeiro 20770-240,brazil
- Industry
- Pharmaceutical Manufacturing
- NAICS
-
Pharmaceutical and Medicine ManufacturingMedicinal and Botanical ManufacturingPharmaceutical Preparation ManufacturingIn-Vitro Diagnostic Substance ManufacturingBiological Product (except Diagnostic) Manufacturing
- Website
- https://www.wasserfarma.com.br/
- HQ
- Rio de Janeiro, Rio de Janeiro